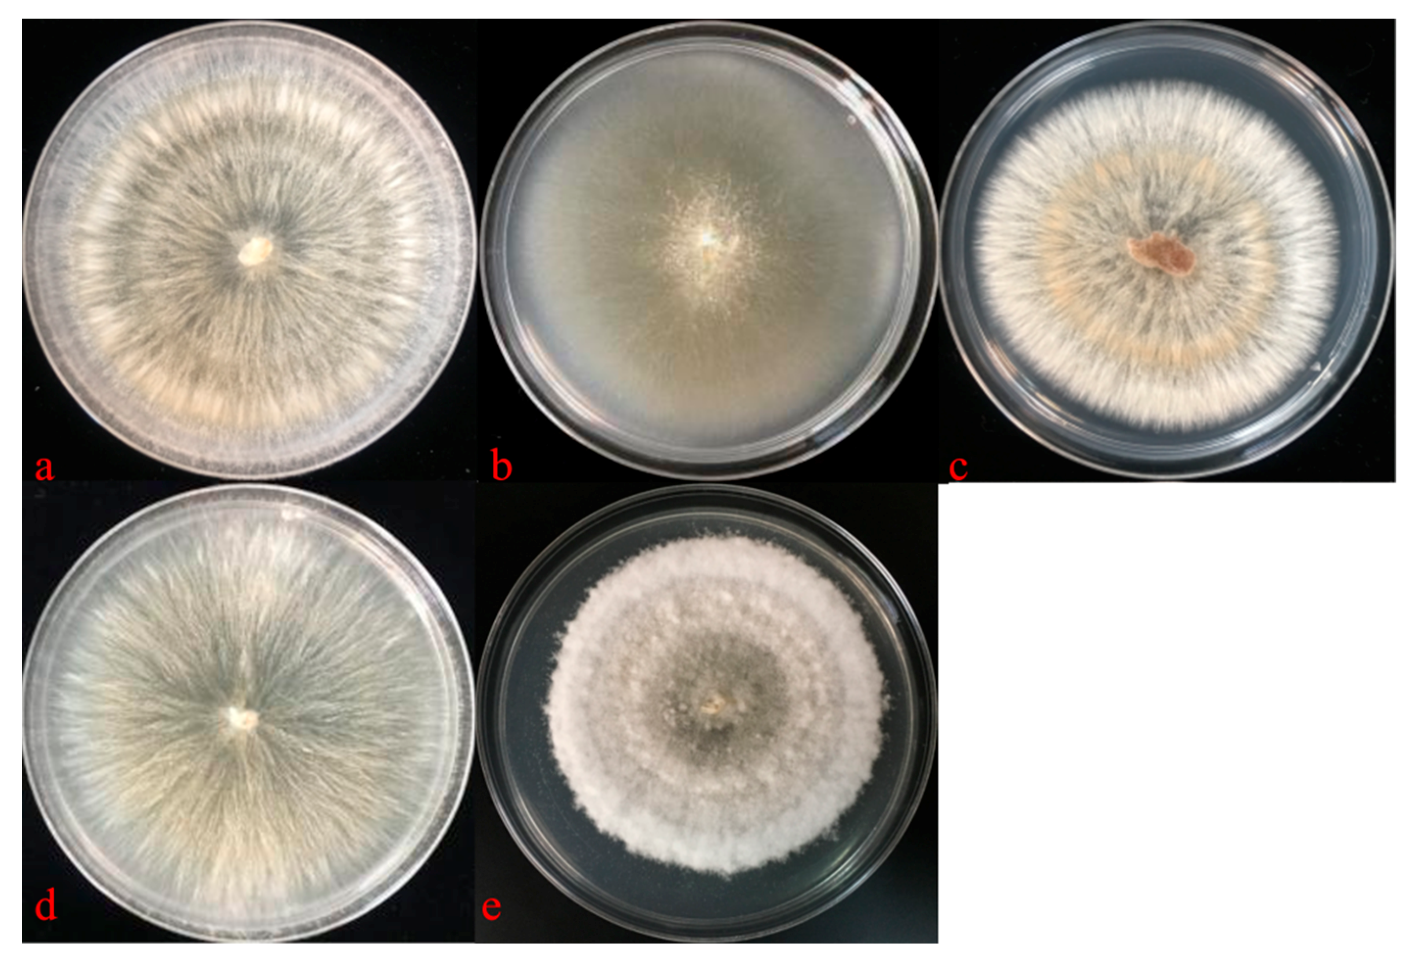
Diversity 13 00197 g005

Abstract
Root-associated endophytic fungi (RAF) are found asymptomatically in almost all plant groups. However, little is known about the compositions and potential functions of RAF communities associated with most Orchidaceae species. In this study, the diversity of RAF was examined in four wild epiphytic orchids, Acampe rigida, Doritis pulcherrima, Renanthera coccinea, and Robiquetia succisa, that occur in southern China. A culture-independent method involving Illumina amplicon sequencing, and an in vitro culture method, were used to identify culturable fungi. The RAF community diversity differed among the orchid roots, and some fungal taxa were clearly concentrated in a certain orchid species, with more OTUs being detected. By investigating mycorrhizal associations, the results showed that 28 (about 0.8%) of the 3527 operational taxonomic units (OTUs) could be assigned as OMF, while the OTUs of non-mycorrhizal fungal were about 99.2%. Among the OMFs, Ceratobasidiaceae OTUs were the most abundant with different richness, followed by Thelephoraceae. In addition, five Ceratobasidium sp. strains were isolated from D. pulcherrima, R. succisa, and R. coccinea roots with high separation rates. These culturable Ceratobasidium strains will provide materials for host orchid conservation and for studying the mechanisms underlying mycorrhizal symbiosis.
1. Introduction
Endophytic fungi in living plants are found at certain stages of the life cycle without causing obvious disease symptoms [1]. Endophytic fungi are found in almost all plant groups, and are an important part of plant microecosystems. Orchidaceae is one of the most diverse families of angiosperms [2]. Endophytic fungi are ubiquitous in the roots of Orchidaceae plants and are involved in the whole life cycle from seed germination to plant growth and development [3,4]. Most Orchidaceae mycorrhizal fungi (OMF) colonize the root cortex cells of orchids in the form of a knot or spiral hyphae. These hyphae offer nutrition for the orchids and promote plant growth, and thus can form symbioses with the orchids [5]. The classical OMF mainly belong to Ceratobasidiaceae, Tulasnellaceae, and Sebacinales (Basidiomycota, Agaricomycetes). In recent years, OMF have gradually become a popular focal point in the biological research of Orchidaceae species [6]. Researchers have extended OMF to include other fungal families such as Thelephoraceae, Russulaceae, Sebacinaceae, Cortinariaceae, and Clavulinaceae [7,8,9].
In addition to OMF, the roots of orchids harbor fungal endophytes that are referred to as root-associated endophytic fungi (RAF) [10]. RAF have mainly been found in the velamen [5,11,12], and do not form typical anatomical features in orchid roots [13,14]. No close phylogenetic relationships have been found between RAF and known OMF [10,15,16,17]. Compared with mycorrhizal fungi, non-mycorrhizal RAF in orchids roots have been found to be more diverse and abundant [14,17,18,19]. Most RAF belong to Ascomycota, within the classes Sordariomycetes, Dothideomycetes, and Leotiomycetes [17,20].
Endophytic fungi have been reported in some Orchidaceae species. Among them, Fusarium, Xylaria, Alternaria, Phoma, and Colletotrichum are prevalent and are the dominant RAF species in many orchid plants, such as those belonging to the genera Anoectochilus, Bletilla, Cleisostoma, Coelogyne, Eria, Gastrochilus, Gymnadenia, Vanda [21,22], and Dendrobium [23]. Some of these reported RAF can promote the absorption of rhizosphere soil nutrients by orchids [24,25]. Furthermore, some of the reported RAF could affect the yield or cause changes to secondary metabolites [26] and are considered to be a resource of bioactive compounds that protect the host from soil pathogens [20]. Some pathogenic Fusarium species have been shown to behave as OMF; they have been found to stimulate seed germination in the orchids Bletilla striata [27] and Cypripedium reginae [28], and to establish colonization and produce pelotons within the cortical cells of Eulophia alta [29], Cattleya skinneri, Brassavola nodosa [30], B. striata, and Dendrobium candidum [27].
The host plant species and geographical region are two important factors that determine the population structure of root endophytic fungi. Moreover, it has been reported that endophytic fungi are especially abundant in the tropics [31]. China’s Hainan Island is on the northern edge of the tropics (18°10′–20°10′ N; 108°37′–111°03′ E), and is mainly affected by the tropical monsoon climate. The natural conditions of Hainan Island in China are advantageous for the growth of wild Orchidaceae species. Therefore, Hainan Island is one of the greatest places to study orchid biodiversity in the world [32,33].
The four orchid species, Doritis pulcherrima Lindl., Acampe rigida (Buch.-Ham. ex J. E. Smith) P. F. Hunt, Renanthera coccinea Lour., and Robiquetia succisa Lindl., are mainly distributed in tropical and subtropical regions; China’s Hainan Island is one of their important habitats. Although these four orchid species have high ornamental and horticultural value, they are rare and endangered in China. Endophytic fungi play an important role in orchid health. Therefore, it is vital to identify the endophytic fungal communities and cultivable growth-promoting fungal strains associated with endangered orchid plants in order to understand how to maintain orchid biodiversity and promote the stability of orchid communities.
In this study, Illumina amplicon sequencing and culture methods were used to isolate and genetically identify the fungal taxa associated with the roots of the selected orchid species. Moreover, different Ceratobasidium species isolated from terrestrial orchids in China were assessed according to their ability to promote germination. To the best of our knowledge, this is the first study on the RAF of A. rigida, R. coccinea, and R. succisa in South China.
2. Materials and Methods
2.1. The Habitat and Sampling of the Terrestrial Orchids
Jianfengling, which is located in the southwest of Hainan Island in China, is one of the few remaining large and well-preserved tropical virgin forests. Jianfengling is characterized by complex vegetation types, and rich and diverse orchids [34]. Healthy populations of the epiphytic orchids A. rigida, D. pulcherrima, R. coccinea, and R. succisa that were located in the Jianfengling National Nature Reserve of Hainan in China, were used in this study. The roots of five individuals of each orchid species were sampled in July 2019 at the end of the flowering stage. All collected roots were washed under running water and carefully brushed in order to remove soil debris. The roots were then soaked in 75% ethanol for 40 s to disinfect the surface. The mycorrhizal morphology of the fresh root samples was observed on thin cross-sections under a light microscope (Leica DFC450 C, Leica Microsystems Ltd., Wetzlar, Germany) using 200 times magnification. Root fragments exhibiting high fungal colonization were immediately processed for fungal isolation. Part of the root material was frozen in liquid nitrogen and stored at −80 °C prior to DNA extraction for high-throughput sequencing.
2.2. Amplicon Sequencing and Analysis of RAF
DNA extraction and PCR amplification: Microbial DNA was extracted using HiPure Soil DNA Kits (Magen, Guangzhou, China) according to manufacturer’s protocols. The DNA concentration and purity were determined using a spectrophotometer (Nanodrop ND-1000; Thermo Fisher Scientific, Wilmington, DE). DNA samples with an absorbance ratio between 1.8 and 2.0 at OD 260/280 and of less than 2.0 at OD 260/230 were used for further analysis. Samples without smears on the 1.5% agarose gel were used for subsequent experiments. The internal transcribed spacer 2 (ITS2) region of the ribosomal DNA gene amplicons was amplified by PCR. The PCR protocol was as follows: 94 °C for 2 min, followed by 30 cycles at 98 °C for 10 s, 62 °C for 30 s, and 68 °C for 30 s, and a final extension at 68 °C for 5 min. The primers ITS3_KYO2 (5′-GATGAAGAACGYAGYRAA-3′) and ITS4 (5′-TCCTCCGCTTATTGATATGC-3′) were used for the PCR [35].
Illumina amplicon sequencing: Amplicons were extracted from 2% agarose gels and purified using AMPure XP Beads (Axygen Biosciences, Union City, CA, USA) according to the manufacturer’s instructions. Quantification was performed using an ABI StepOnePlus Real-Time PCR System (Life Technologies, Foster City, CA, USA). Purified amplicons were pooled in equimolar ratios and paired-end sequenced (PE250) on an Illumina platform according to the standard protocols. The raw reads were deposited into the National Center for Biotechnology Information (NCBI) Sequence Read Archive (SRA) database (Accession Number: PRJNA688805).
Quality control and read assembly: Raw data containing adapters or low-quality reads would affect the subsequent assembly and analysis. Thus, to obtain high-quality clean reads, the raw reads were further filtered. Reads were removed if they exhibited >10% of unknown nucleotides and if <50% of the bases had a Q-value > 20. The filtering was performed using FASTP v0.18.0 [36]. Paired-end clean reads were merged as raw tags using FLASH v1.2.11 [37] with a minimum overlap of 10 bp and mismatch error rates of 2%. Noisy raw tag sequences were filtered using the QIIME v1.9.1 [38] pipeline under specific filtering conditions [39] to obtain the high-quality clean tags. The filtering conditions were as follows: (1) raw tags were broken from the first low-quality base site where the number of bases in the continuous low-quality value (default quality threshold ≤ 3) reached the set length (default length = 3) and (2) tags with a continuous high-quality base length of less than 75% of the tag length were filtered.
Operational taxonomic unit (OTU) and community composition analysis: The effective tags were clustered into OTUs according to a similarity threshold of 97% using the UPARSE v9.2.64 pipeline [40]. The tag sequence with the highest abundance was selected as the representative sequence within each cluster. The higher the Shannon value, the greater the community diversity. The higher the Chao value, the greater the number of OTUs contained in the community and the greater the richness of the community. The Shannon and Chao alpha diversity index values were calculated using QIIME v1.9.1 [38]. UpSet plot analysis was performed using the R project UpSetR package v1.3.3 [41] to identify unique and common OTUs between groups.
The representative sequences were assigned to taxa by a naive Bayesian model of the RDP classifier v2.2 [42] using the Greengenes database vgg_13_5 [43]. A confidence threshold value of 0.8–1 was used. The abundance statistics of each taxon were visualized using Krona v2.6 [44]. A heatmap of species abundance was plotted using the Pheatmap package v1.0.12 [45] in R.
2.3. Isolation and Identification of Culturable Endophytic Fungi
The endophytic fungi were isolated from the normal underground roots of five individual plants of each orchid species. The roots were cut into 5 cm segments, and flushed with running water for 2 h. The segments were then surface sterilized in a Clean Bench by consecutive immersion for 30 s in 75% ethanol, for 3 min in 2% sodium hypochlorite, and five times in sterile water. The root samples were cut into 1–2 mm long segments. In total, 1052 segments were used for endophyte isolation in this study. Sets of eight segments were evenly placed in a 90 mm Petri dish containing potato dextrose agar (PDA; 2%). Benzylpenicillin sodium (50 mg/L; North China Pharmaceutical Group Corporation, Shijiazhuang, China) was added to suppress bacterial growth. The Petri dishes were sealed, incubated at 25 °C, and examined periodically. When fungal colonies developed, they were transferred to new PDA-containing Petri dishes for purification.
The purified fungal isolates were identified based on their morphological characteristics and transferred to PDA slants for further study. One representative strain of each morphotype was selected for further molecular identification. The DNA extraction was performed as described above. The ITS2 sequences were amplified using the primers ITS1F and ITS4R, sequenced via the Sanger sequencing method, and identified using NCBI BLAST according to the methods of Chen et al. [21].
3. Results
3.1. Distribution of Endophytic Fungi in Root Cells
Most OMF colonize the orchid root cortex cells in the form of knot or spiral hyphae. Light microscopy using thin sections showed that the roots of all four orchid samples were extensively colonized by fungal hyphae (Figure 1). Characteristic dense intracellular hyphal coils (pelotons) were observed in most orchid root cortical cells (Figure 1b,e,h,k). Moreover, intercellular hyphae spanning different cells were observed at 400-fold magnification (Figure 1c).
Figure 1.
The wild plants and intracellular fungal pelotons in the roots of four orchid species. Photographs of the plants and fungal pelotons are shown for Doritis pulcherrima (a–c), Acampe rigida (d–f), Renanthera coccinea (g–i), and Robiquetia succisa (j–l) plants from Jianfengling National Nature Reserve of Hainan in China. The blue dotted boxes indicate the areas containing the intracellular fungal pelotons. The blue arrows indicate the cell walls of the orchid roots. The red arrows indicate the intracellular fungal pelotons of the orchid roots.
3.2. RAF Diversity
After quality filtering and chimera removal, 793,687 high-quality sequences were obtained and could be assigned to the different samples. The number of sequences per individual sample varied from 56,112 to 73,556. A total of 3527 OTUs were identified at 97% sequence similarity (Table 1 and Table S1). There were 1060 OTUs in D. pulcherrima (Dor), 942 OTUs in R. coccinea (Ren), 1256 OTUs in A. rigida (Aca), and 1500 OTUs in R. succisa (Rob) roots. There were more RAF OTUs in the R. succisa roots than in the roots of the other orchids.
Table 1.
All tags and operational taxonomic units (OTUs) in the roots of four wild orchid species.
The endophytic fungal community diversity (Shannon; Figure 2a) and richness (Chao; Figure 2b) index values of all samples were calculated to illustrate the complexity of each sample’s fungal community. In this study, the Shannon index values of the RAF communities differed among the sampled orchids roots (Figure 2a), but these differences were not significant. The Chao index values significantly differed between the Rob and Aca root samples. The Chao index values of the RAF communities were also extremely significantly different (p < 0.01) between Rob and Dor and between Rob and Ren roots (Figure 2b).
Figure 2.
The diversity and richness of orchid root-associated fungal (RAF) communities. The Shannon (a) and Chao (b) index values of the fungal operational taxonomic units (OTUs) obtained from different root samples of wild Acampe rigida (Aca), Doritis pulcherrima (Dor), Renanthera coccinea (Ren) and Robiquetia succisa (Rob) plants from Jianfengling National Nature Reserve of Hainan in China. The dots indicated the outliers.
An UpSet diagram was constructed to highlight the similarities and differences in communities among the different orchid roots. In the wild R. succisa root, the number of species-specific fungal OTUs was the highest (1209 OTUs). This was followed by the A. rigida roots with 735 specific OTUs and the D. pulcherrima roots with 558 specific OTUs. The wild R. coccinea roots had the fewest specific fungal OTUs at 486 (Figure 3). Of all the detected RAF OTUs, 43 were common to the roots of all four orchids. There were significant differences in the numbers of OTUs that were common between two species; Ren and Dor shared 111 OTUs while Ren and Rob shared only 12, with most belonging to the Trichocomaceae family. The large number of common OTUs among samples from different orchid roots indicates that some colonization patterns may be conserved during long-term evolution.
Figure 3.
Common and specific fungal operational taxonomic units (OTUs) among the roots of four wild orchids. The orchids studied were Doritis pulcherrima (Dor), Renanthera coccinea (Ren), Acampe rigida (Aca), and Robiquetia succisa (Rob). The dots indicate the specific OTUs and the lines indicate the common OTUs.
The diversity and community composition of colonizing endophytic fungi is affected by the host species. The heatmap revealed that the occurrence of some relatively abundant RAF OTUs was biased among plant roots (Figure 4). The relative abundance of different taxa significantly differed between root samples. Chytridiomycota was the dominant phylum in the D. pulcherrima root, followed by Mucoromycota and Ascomycota. Ascomycota was the dominant phylum in the roots of the other three sampled orchids.
Figure 4.
The distribution of different fungal taxa among orchid roots. The heatmap shows the distribution of relatively abundant fungal operational taxonomic units (OTUs; >1000 reads) among the roots of the four wild orchid species. The diversity of the endophytic fungi at different taxonomic levels ((a) phylum, (b) family, and (c) genus level).
The diversity of the RAF at the family level clearly differed between samples. There were seven dominant families in A. rigida roots, including Stictidaceae, Vibrisseaceae, and Capnodiaceae. In the D. pulcherrima roots, the dominant families were Teratosphaeriaceae, Umbelopsidaceae, and Cordycipitaceae. There were seven dominant families in the R. coccinea roots, including Schizoparmaceae, Cladosporiaceae, and Helotiaceae. In the R. succisa roots, there were eight dominant families, including Bionectriaceae, Xylariaceae, and Lophiostomataceae.
The diversity of the RAF at the genus level also clearly differed between samples. Among the endophytic fungi, Cylindrocarpon, Paraconiothyrium, Alloconiothyrium, and 10 other genera mainly occurred in the A. rigida roots. Papiliotrema, Fusarium, Trichomerium, and three other genera mainly occurred in the D. pulcherrima roots. Rhizoctonia, Deniquelata, Parapharosphaeria, and seven other genera mainly occurred in the R. coccinea roots. Neopestalotiopsis, Pestalotiopsis, Devriesia, and 11 other genera mainly occurred in the R. succisa roots.
3.3. OMF Identities
In total, 297 OTUs were obtained that corresponded to sequences of Basidiomycota. Of these, 28 (about 0.8% of the 3527) OTUs could be assigned as OMF according to Dearnaley et al. [7]. The majority of the detected OMF (16 OTUs) belonged to the Ceratobasidiaceae family. In addition, a number of other ectomycorrhizal taxa that have previously been shown to be associated with these orchid species were detected. These ectomycorrhizal taxa included Thelephoraceae (10 OTUs), Russulaceae (two OTUs), and Sebacinaceae (two OTUs). The relative abundances of the 28 OMF OTUs are listed in Table 2. However, the abundances of these fungal families differed between root samples. Ceratobasidiaceae were dominant community members in the wild R. succisa and R. coccinea roots. For example, 29,765 sequences were detected for Otu000006, which was annotated as belonging to Ceratobasidiaceae, in the R. succisa root samples. This was followed by the 221 Otu000006 sequences detected in the R. coccinea roots. Otu000263 and Otu000506 also belonged to the Ceratobasidiaceae family, and 528 and 224 sequences, respectively, were detected for these OTUs in the R. coccinea root samples. Meanwhile, members of Thelephoraceae and Sebacinaceae dominated the mycorrhizal community associated with the A. rigida root. Russulaceae OTUs were detected only in A. rigida (one OTU) and D. pulcherrima (two OTUs) roots (Table 2).
Table 2.
Tag numbers of the operational taxonomic units (OTUs) corresponding to the orchid-associated mycorrhizal families identified.
3.4. Culturable Endophytic Fungi from the Orchid Roots
Using separation and cultivation methods, five Ceratobasidium strains were isolated from D. pulcherrima (Cer1 and Cer4), R. succisa (Cer2 and Cer3), and R. coccinea (Cer5) roots (Table 3 and Figure 5a–e) with separation rates of more than 70%. However, in the A. rigida roots, Ceratobasidium species have not yet been separated.
Table 3.
Operational taxonomic units (OTUs) of fungi isolated from the four orchids and their possible identities. Internal transcribed spacer (ITS) sequencing was performed, and sequences were annotated to assess the fungi present in the root samples of four orchid species.
Figure 5.
Colony morphology of some of the fungi isolated from the wild orchids. The fungi, which had been recovered from the roots of the four sampled epiphytic orchids, were cultivated on potato dextrose agar (PDA). (a) Ceratobasidium sp. Cer1 from Doritis pulcherrima, (b) Ceratobasidium sp. Cer2 from Renanthera coccinea, (c) Ceratobasidium sp. Cer3 from R. coccinea, (d) Ceratobasidium sp. Cer4 from D. pulcherrima, and (e) Ceratobasidium sp. Cer5 from Robiquetia succisa.
The ITS2 sequences of the Cer1 and Cer4 isolates (Otu004661) matched that of Ceratobasidium sp. isolate 85 with different identity index values. Ceratobasidium sp. isolate 85 was originally found as a Triticum aestivum RAF in Azerbaijan. The ITS2 sequence of the Cer2 isolate (Otu004340) matched that of Ceratobasidium sp. AG-G isolate Str14, which was originally found to be associated with Fragaria x ananassa in Israel. The ITS2 sequence of the Cer3 isolate completely matched to that of Ceratobasidium sp. FPUB 168, which was isolated from the endangered orchid, Dactylorhiza hatagirea, from India. The NCBI ITS BLAST identity index value showed that there was up to 99.83% similarity between the Cer5 isolate and Ceratobasidium sp. M-13 from the roots of Rhynchostylis retusa (Orchidaceae) of China.
4. Discussion
RAF are important functional fungi within ecosystems [46,47], have a high level of taxonomic diversity [48], and are especially abundant in the tropics [31]. RAF are known to affect plant community diversity and structure [49]. Studying the RAF diversity and specific RAF in tropical orchids is helpful for revealing the mechanism underlying the maintenance of tropical orchid population diversity.
In this study, Illumina amplicon sequencing was used to identify orchid RAF. Numerous common RAF were found among the sampled orchid species. The results presented here are similar to those of Yang et al. [50], who found comparable numbers of RAF OTUs in plants roots growing in similar tropical forest habitats on Hainan Island, China. However, the taxonomic compositions found were somewhat different. Moreover, many of the identified RAF have been separated from the medicinal plant D. sinense, which is endemic to Hainan [51], and from the epiphytic orchid Oxystophyllum changjiangense [52]. The RAF, which were highly abundant in most of the four epiphytic orchids in this study, were also found in Bletilla striata in Yunnan [53], in Gymnadenia conopsea in Beijing [36], and in three medicinal Orchidaceae species, D. nobile, D. chrysanthum, and Anoectochilus roxburghii, from different areas of southwest China [21]. The results of this study were also in agreement with those of previous studies in that wild D. pulcherrima has frequently been found to associate with common RAF such as Fusarium and Alternaria [54]. This is in line with the results for the epiphytic orchids of the genera Gastrochilus, Cleisostoma, Eria, Coelogyne, and Vanda [22]. These results indicate that some RAF might be widely distributed across different host orchid species and geographically.
Although many orchid species share common RAF partners, the RAF community composition and richness varied among the tropical epiphytic plants, and significant host specificity was confirmed. The species richness of various endophytic fungi was significant different in orchid species. Some fungal taxa were clearly concentrated in certain orchid species, with more OTUs being detected. For example, at the family level, Agaricaceae and Helotiaceae fungi were concentrated in R. coccinea, Teratosphaeriaceae and Umbelopsidaceae were concentrated in D. pulcherrima, Bionectriaceae, and Xylariaceae were concentrated in R. succisa, and Nectriaceae in A. rigida roots. These fungi are common plant endophytes. The results demonstrated that there were distinct endophyte community compositions and richness in host plants, suggesting that host preferences become more specific during long-term evolution [48,55,56].
OMF are mainly distinguished as being non-mycorrhizal RAF, and they are represented in much smaller numbers than RAF in orchid roots [14,17,18], similar to those of this study. Otero et al. found that 80% of fungal isolates from roots of epiphytic orchids from Puerto Rico were non-mycorrhizal endophytes [19]. In addition, Novotna et al. found about 92% OTUs of non-mycorrhizal RAF from three epiphytic orchids in southern Ecuador [17]. Some low abundance OMF might be not detected by using the culture-independent method involving Illumina sequencing and bioinformatic analysis, which might be one of the reasons for the lower number of OMF relative to non-mycorrhizal fungi in this study.
Mycorrhizal fungi tend to form mutualistic symbiotic relationships with the host plant. Not only can OMF form symbioses with typical structural characteristics (circular hyphal structures) within host orchid plants, but they also perform nutrient exchange with the host plants. Thus, the relationship between OMF and the host plant is closely linked to plant growth and development. The most common OMF belong to Ceratobasidiaceae, Tulasnellaceae, and Sebacinales, and to a lesser extent to Thelephoraceae. These OMF are the prime associates in a wide number of related orchid species. For example, Anacamptis laxiflora, Ophrys fuciflora, and species of the genus Orchis have been shown to be associated predominantly with Ceratobasidiaceae and Tulasnellaceae [57,58].
In the present study, the investigation of mycorrhizal associations using ITS amplicon sequencing showed that numerous Ceratobasidiaceae OTUs were associated with all four of the studied orchids. Thelephoraceae OTUs were also highly abundant (Table 3). However, OTUs of the other most-reported OMF members of Tulasnellaceae and Sebacinales were not observed. This could be attributed to the primer bias against this fungal group [59]. The ITS3/ITS4 primer pair may exclude Tulasnellaceae at PCR amplification, which might be another reason for the lower ratio of OMF in this study. Multigene primer pairs should be considered to reduce the data error caused by primer bias in future studies. Similarly, using separation and cultivation methods, it was found in the present study that members of Ceratobasidiaceae were the dominant fungi associated with D. pulcherrima, R. coccinea, and R. succisa. No Ceratobasidiaceae members were isolated from the A. rigida roots in the present study. Similarly, Ke et al. [54] were not successful in obtaining the most common culturable OMF strains.
Ceratobasidioid fungi have been previously found to associate with several other orchid species [19,58,60], such as the epiphytic orchids Oncidium [61], Ionopsis [19,62,63], Dendrophylax [64,65], and the leafless orchid genus Campylocentrum [19,66]. Ceratobasidioid fungi have also been found in terrestrial orchids of both forest and meadow habitats, including Goodyera [67,68,69], Neuwiedia [70], Cephalanthera, and Orchis [60,71,72]. In previous studies, extensive symbioses have been found between orchids and Ceratobasidium fungi. A Ceratobasidium sp. strain isolated from the Trichoceros antennifer orchid was found to promote the seed germination of E. secundum [73]. Ceratobasidium species isolated from wild Cymbidium ensifolium could colonize within the roots and significantly increase the fresh weight of C. ensifolium, C. mannii, and D. officinale (Orchidaceae) seedlings on OMA medium [74]. In view of these, in the future, the culturable Ceratobasidium sp. strains in this study will be worth paying close attention to, with respect to their potential symbiotic mechanisms with their host orchids.
5. Conclusions
In the present study, the diversity of RAF in four wild tropical epiphytic orchid species located in southern China were examined by Illumina amplicon sequencing and culturing methods. The results showed that the colonization diversity, species richness, and community composition of the RAF varied among the four orchid species. The results of investigating OMF associations showed that Ceratobasidiaceae OTUs were the most abundant, followed by Thelephoraceae OTUs, and the culturable Ceratobasidium sp. isolates also had the higher separation rates. There were many more RAF than OMF species detected in the four orchids—about 99.2% OTUs of non-mycorrhizal fungal contrasting with 0.8% OTUs of potential OMF. Unfortunately, OTUs were not observed for Tulasnellaceae species, which are other commonly reported OMF. This study might provide potential clues and culturable strain resources for endangered host orchid conservation in the future.
Supplementary Materials
The following are available online at https://www.mdpi.com/article/10.3390/d13050197/s1, Table S1: All of the OTU sequences, profiling and annotations.
Author Contributions
Conceptualization, T.W.; methodology, T.W. and M.C.; software, T.W.; validation, T.W., M.C. and Y.Y.; investigation, Y.Z.; resources, T.W. and Y.Z.; data curation, T.W.; writing—original draft preparation, T.W.; writing—review and editing, T.W.; supervision, L.G. and D.L.; project administration, T.W.; funding acquisition, T.W. All authors have read and agreed to the published version of the manuscript.
Funding
This work was funded by grants from the Beijing Botanical Garden (grant number BZ201901) and Beijing Municipal Administration Center of Parks (grant number ZX2020006) in China.
Institutional Review Board Statement
Not applicable.
Informed Consent Statement
Not applicable.
Data Availability Statement
Not applicable.
Acknowledgments
We thank the experts of the Jianfengling Forestry Bureau of Hainan Province in China for assistance with sample collection.
Conflicts of Interest
The authors declare no conflict of interest.
References
- Wilson, D. Endophyte: The Evolution of a Term, and Clarification of Its Use and Definition. Oikos 1995, 73, 274. [Google Scholar] [CrossRef]
- Chen, X.Q.; Liu, Z.J.; Luo, Y.B.; Jin, X.H.; Ji, Z.H. A Field Guide to the Orchids of China; China Forestry Publishing House: Beijing, China, 2009; pp. 1–160. [Google Scholar]
- Rasmussen, H.N.; Dixon, K.W.; Jersáková, J.; Těšitelová, T. Germination and seedling establishment in orchids: A complex of requirements. Ann. Bot. 2015, 116, 391–402. [Google Scholar] [CrossRef]
- Fay, M.F. Orchid conservation: Further links. Ann. Bot. 2016, 118, 89–91. [Google Scholar] [CrossRef]
- Smith, S.E.; Read, D.J. Mycorrhizal Symbiosis; Academic Press: San Diego, CA, USA, 1997. [Google Scholar]
- Gebauer, G.; Preiss, K.; Gebauer, A.C. Partial mycoheterotrophy is more widespread among orchids than previously assumed. New Phytol. 2016, 211, 11–15. [Google Scholar] [CrossRef]
- Dearnaley, J.D.W.; Martos, F.; Selosse, M.-A. 12 Orchid Mycorrhizas: Molecular Ecology, Physiology, Evolution and Conservation Aspects. In Fungal Associations; Springer Science and Business Media LLC: Berlin/Heidelberg, Germany, 2012; pp. 207–230. [Google Scholar]
- Ogura-Tsujita, Y.; Yokoyama, J.; Miyoshi, K.; Yukawa, T. Shifts in mycorrhizal fungi during the evolution of autotrophy to mycoheterotrophy in Cymbidium (Orchidaceae). Am. J. Bot. 2012, 99, 1158–1176. [Google Scholar] [CrossRef]
- Chen, Y.; Gao, Y.; Song, L.; Zhao, Z.; Guo, S.; Xing, X. Mycorrhizal fungal community composition in seven orchid species inhabiting Song Mountain, Beijing, China. Sci. China Life Sci. 2019, 62, 838–847. [Google Scholar] [CrossRef] [PubMed]
- Kohout, P.; Těšitelová, T.; Roy, M.; Vohník, M.; Jersáková, J. A diverse fungal community associated with Pseudorchis albida (Orchidaceae) roots. Fungal Ecol. 2013, 6, 50–64. [Google Scholar] [CrossRef]
- Suárez, J.P.; Weiß, M.; Abele, A.; Garnica, S.; Oberwinkler, F.; Kottke, I. Diverse tulasnelloid fungi form mycorrhizas with epiphytic orchids in an Andean cloud forest. Mycol. Res. 2006, 110, 1257–1270. [Google Scholar] [CrossRef] [PubMed]
- Suárez, J.P.; Weiss, M.; Oberwinkler, F.; Kottke, I. Epiphytic orchids in a mountain rain forest in southern Ecuador harbor groups of mycorrhiza-forming Tulasnellales and Sebacinales subgroup B (Basidiomycota). In Proceedings of the Second Scientific Conference on Andean Orchids; Universidad Técnica Particular de Loja: Loja, Ecuador, 2009; pp. 184–196. [Google Scholar]
- Addy, H.D.; Piercey, M.M.; Currah, R.S. Microfungal endophytes in roots. Can. J. Bot. 2005, 83, 1–13. [Google Scholar] [CrossRef]
- Bayman, P.; Otero, J.T. Microbial Endophytes of Orchid Roots; Schulz, B., Boyle, C., Sieber, T.N., Eds.; Springer: Berlin, Germany, 2006. [Google Scholar]
- Yagame, T.; Orihara, T.; Selosse, M.; Yamato, M.; Iwase, K. Mixotrophy of Platanthera minor an orchid associated with ectomycorrhiza-forming Ceratobasidiaceae fungi. New Phytol. 2012, 193, 178–187. [Google Scholar] [CrossRef] [PubMed]
- Cowden, C.C.; Shefferson, R.P. Diversity of root-associated fungi of mature Habenaria radiata and Epipactis thunbergii colonizing manmade wetlands in Hiroshima Prefecture, Japan. Mycoscience 2013, 54, 327–334. [Google Scholar] [CrossRef]
- Novotná, A.; Benítez, Á.; Herrera, P.; Cruz, D.; Filipczyková, E.; Suárez, J.P. High diversity of root-associated fungi isolated from three epiphytic orchids in southern Ecuador. Mycoscience 2018, 59, 24–32. [Google Scholar] [CrossRef]
- Jumpponen, A. Non-mycorrhizal root endophytes-aspects on their ecology. In Proceedings of the 7th International Mycological Congress, Oslo, Norway; Springer: Berlin, Germany, 2002. [Google Scholar]
- Otero, J.T.; Ackerman, J.D.; Bayman, P. Diversity and host specificity of endophytic Rhizoctonia -like fungi from tropical orchids. Am. J. Bot. 2002, 89, 1852–1858. [Google Scholar] [CrossRef]
- Ma, X.Y.; Kang, J.C.; Nontachaiyapoom, S.; Wen, T.; Hyde, K.D. Non-mycorrhizal endophytic fungi from orchids. Curr. Sci. 2015, 109, 72–87. [Google Scholar]
- Chen, J.; Meng, Z.X.; Xing, Y.M.; Guo, S.X. Isolation and Identification of Endophytic Fungi from Five Medicinal Plants Species of Orchidaceae. Chin. J. Pharm. 2017, 52, 267–271. [Google Scholar]
- Feng, X.X.; Chen, J.J.; Liu, F.; Hu, W.Z.; Lin, F.C.; Zhang, C.L. Diversity of non-mycorrhizal endophytic fungi from five epiphytic orchids from Xishuangbanna, China. Mycosystema 2019, 38, 1876–1885. [Google Scholar]
- Yuan, Z.-L.; Chen, Y.-C.; Yang, Y. Diverse non-mycorrhizal fungal endophytes inhabiting an epiphytic, medicinal orchid (Dendrobium nobile): Estimation and characterization. World J. Microbiol. Biotechnol. 2009, 25, 295–303. [Google Scholar] [CrossRef]
- Newsham, K.K. A meta-analysis of plant responses to dark septate root endophytes. New Phytol. 2011, 190, 783–793. [Google Scholar] [CrossRef] [PubMed]
- Zhao, X.-L.; Yang, J.-Z.; Liu, S.; Chen, C.-L.; Zhu, H.-Y.; Cao, J.-X. The colonization patterns of different fungi on roots of Cymbidium hybridum plantlets and their respective inoculation effects on growth and nutrient uptake of orchid plantlets. World J. Microbiol. Biotechnol. 2014, 30, 1993–2003. [Google Scholar] [CrossRef]
- Zhang, F.-S.; Lv, Y.-L.; Zhao, Y.; Guo, S.-X. Promoting role of an endophyte on the growth and contents of kinsenosides and flavonoids of Anoectochilus formosanus Hayata, a rare and threatened medicinal Orchidaceae plant. J. Zhejiang Univ. Sci. B 2013, 14, 785–792. [Google Scholar] [CrossRef] [PubMed]
- Jiang, J.; Zhang, K.; Cheng, S.; Nie, Q.; Zhou, S.-X.; Chen, Q.; Zhou, J.; Zhen, X.; Li, X.T.; Zhen, T.W.; et al. Fusarium oxysporum KB-3 from Bletilla striata: An orchid mycorrhizal fungus. Mycorrhiza 2019, 29, 531–540. [Google Scholar] [CrossRef]
- Vujanovic, V.; St-Arnaud, M.; Barabé, D.; Thibeault, G. Viability Testing of Orchid Seed and the Promotion of Colouration and Germination. Ann. Bot. 2000, 86, 79–86. [Google Scholar] [CrossRef]
- Johnson, T.R.; Stewart, S.L.; Dutra, D.; Kane, M.E.; Richardson, L. Asymbiotic and symbiotic seed germination of Eulophia alta (Orchidaceae)—Preliminary evidence for the symbiotic culture advantage. Plant Cell Tissue Organ Cult. 2007, 90, 313–323. [Google Scholar] [CrossRef]
- Ovando, I.; Damon, A.; Bello, R.; Ambrosio, D.; Albores, V.; Adriano, L.; Salvador, M. Isolation of endophytic fungi and their potential for the tropical epiphytic orchids Cattleya skinneri, C. aurantiaca and Brassavola nodosa. Asian J. Plant Sci. 2005, 4, 309–315. [Google Scholar] [CrossRef]
- Arnold, A.E. Understanding the diversity of foliar endophytic fungi: Progress, challenges, and frontiers. Fungal Biol. Rev. 2007, 21, 51–66. [Google Scholar] [CrossRef]
- Ding, S.Y.; Lai, Q.X.; Xiao, H.X.; Li, H.W. Investigation report on orchid germplasm resources in Hainan Island. Chin. J. Trop. Crops 1991, 12, 105–111. [Google Scholar]
- Tsi, Z.H.; Chen, X.Q.; Ding, S.Y. Critical and additional notes on orchids of Hainan, China. ACTA Phytotaxon. Sin. 1995, 33, 576–591. [Google Scholar]
- Shi, G.Z.; Zhou, T.F.; Yin, G.T. Distribution and conservation strategies for wild orchid resources in Jianfengling, Hailan Island. J. Fujian For. Sci. Technol. 2008, 35, 203–207. [Google Scholar]
- Toju, H.; Tanabe, A.S.; Yamamoto, S.; Sato, H. High-Coverage ITS Primers for the DNA-Based Identification of Ascomycetes and Basidiomycetes in Environmental Samples. PLoS ONE 2012, 7, e40863. [Google Scholar] [CrossRef]
- Chen, S.; Zhou, Y.; Chen, Y.; Gu, J. fastp: An ultra-fast all-in-one FASTQ preprocessor. Bioinformatics 2018, 34, i884–i890. [Google Scholar] [CrossRef]
- Magoč, T.; Magoč, M.; Salzberg, S.L. FLASH: Fast Length Adjustment of Short Reads to Improve Genome Assemblies. Bioinformatics 2011, 27, 2957–2963. [Google Scholar] [CrossRef]
- Caporaso, J.G.; Kuczynski, J.; Stombaugh, J.; Bittinger, K.; Bushman, F.D.; Costello, E.K.; Fierer, N.; Peña, A.G.; Goodrich, J.K.; Gordon, J.I.; et al. QIIME Allows Analysis of High-Throughput Community Sequencing data. Nat. Methods 2010, 7, 335–336. [Google Scholar] [CrossRef]
- Bokulich, N.A.; Subramanian, S.; Faith, J.J.; Gevers, D.; Gordon, J.I.; Knight, R.T.; Mills, D.A.; Caporaso, J.G. Quality-filtering vastly improves diversity estimates from Illumina amplicon sequencing. Nat. Methods 2013, 10, 57–59. [Google Scholar] [CrossRef]
- Edgar, R.C. UPARSE: Highly accurate OTU sequences from microbial amplicon reads. Nat. Methods 2013, 10, 996–998. [Google Scholar] [CrossRef]
- Conway, J.R.; Lex, A.; Gehlenborg, N. UpSetR: An R package for the visualization of intersecting sets and their properties. Bioinformatics 2017, 33, 2938–2940. [Google Scholar] [CrossRef]
- Wang, Q.; Garrity, G.M.; Tiedje, J.M.; Cole, J.R. Naive Bayesian classifier for rapid assignment of rRNA sequences into the new bacterial taxonomy. Appl. Inviron. Microbiol. 2007, 73, 5261–5267. [Google Scholar] [CrossRef]
- DeSantis, T.Z.; Hugenholtz, P.; Larsen, N.; Rojas, M.; Brodie, E.L.; Keller, K.; Huber, T.; Dalevi, D.; Hu, P.; Andersen, G.L. Greengenes, a chimera-checked 16S rRNA gene database and workbench compatible with ARB. Appl. Environ. Microbiol. 2006, 72, 5069–5072. [Google Scholar] [CrossRef] [PubMed]
- Ondov, B.D.; Bergman, N.H.; Phillippy, A.M. Interactive metagenomic visualization in a Web browser. BMC Bioinform. 2011, 12, 385. [Google Scholar] [CrossRef] [PubMed]
- Kolde, R.; Kolde, M.R. Package Pheatmap 1.0.12. Available online: https://cran.r-project.org/web/packages/pheatmap/index.html (accessed on 4 January 2019).
- Toju, H.; Sato, H.; Yamamoto, S.; Kadowaki, K.; Tanabe, A.S.; Yazawa, S.; Nishimura, O.; Agata, K. How are plant and fungal communities linked to each other in belowground ecosystems? A massively parallel pyrosequencing analysis of the association specificity of root-associated fungi and their host plants. Ecol. Evol. 2013, 3, 3112–3124. [Google Scholar] [CrossRef]
- Almario, J.; Jeena, G.; Wunder, J.; Langen, G.; Zuccaro, A.; Coupland, G.; Bucher, M. Root-associated fungal microbiota of nonmycorrhizal Arabis alpina and its contribution to plant phosphorus nutrition. Proc. Natl. Acad. Sci. USA 2017, 114, E9403–E9412. [Google Scholar] [CrossRef]
- Toghueo, R.M.K.; Boyom, F.F. Endophytic Fungi from Terminalia Species: A Comprehensive Review. J. Fungi 2019, 5, 43. [Google Scholar] [CrossRef]
- Huang, W.Y.; Cai, Y.Z.; Hyde, K.D.; Corke, H.; Sun, M. Biodiversity of endophytic fungi associated with 29 traditional Chinese medicinal plants. Fungal Diver. 2008, 33, 61–75. [Google Scholar]
- Yang, S.Q.; Zhang, Q.; Song, X.Q.; Wang, J.; Li, Y.D.; Xu, H.; Guo, S.Y.; Ding, Q. Structural features of root-associated fungus-plant interaction networks in the tropical montane rain forest of Jianfengling, China (in Chinese). Biodiver. Sci. 2019, 27, 314–326. [Google Scholar]
- Chai, X.L.; Song, X.Q.; Zhu, J. Diversity of Endophytic Fungi Isolated from Dendrobium sinense with Different Culture Media and Their Antimicrobial Activities. Chin. J. Trop. Crops 2018, 39, 137–144. [Google Scholar]
- Li, J.J. Epiphytic characteristic and the diversity of root endophytic fungi of Oxystophyllum changjiangense in Bawangling, Hainan Island. Ph.D. Thesis, Hainan University, Hainan, China, February 2016. [Google Scholar]
- Deng, W.X.; Zhao, M.L.; Li, Y.M.; Wang, Z.L.; Zhang, K.; Zhan, F.D. Diversity of endophytic fungi associated with Bletilla striata roots (in Chinese). Mycosystema 2019, 38, 1907–1917. [Google Scholar]
- Ke, H.L.; Song, X.Q.; Tan, Z.Q.; Liu, H.X.; Luo, Y.B. Endophytic fungi diversity in root of Doritis pulcherrima (Orchidaceae). Biodiv. Sci. 2007, 15, 456–462. [Google Scholar]
- Cohen, S.D. Host Selectivity and Genetic Variation of Discula umbrinella Isolates from Two Oak Species: Analyses of Intergenic Spacer Region Sequences of Ribosomal DNA. Microb. Ecol. 2006, 52, 463–469. [Google Scholar] [CrossRef]
- Maciá-Vicente, J.G.; Ferraro, V.; Burruano, S.; Lopez-Llorca, L.V. Fungal Assemblages Associated with Roots of Halophytic and Non-halophytic Plant Species Vary Differentially Along a Salinity Gradient. Microb. Ecol. 2012, 64, 668–679. [Google Scholar] [CrossRef]
- Girlanda, M.; Segreto, R.; Cafasso, D.; Liebel, H.T.; Rodda, M.; Ercole, E.; Cozzolino, S.; Gebauer, G.; Perotto, S. Photosynthetic Mediterranean meadow orchids feature partial mycoheterotrophy and specific mycorrhizal associations. Am. J. Bot. 2011, 98, 1148–1163. [Google Scholar] [CrossRef]
- Jacquemyn, H.; Honnay, O.; Cammue, B.P.A.; Brys, R.; Lievens, B. Low specificity and nested subset structure characterize mycorrhizal associations in five closely related species of the genus Orchis. Mol. Ecol. 2010, 19, 4086–4095. [Google Scholar] [CrossRef]
- Waud, M.; Busschaert, P.; Ruyters, S.; Jacquemyn, H.; Lievens, B. Impact of primer choice on characterization of orchid mycorrhizal communities using 454 pyrosequencing. Mol. Ecol. Resour. 2014, 14, 679–699. [Google Scholar] [CrossRef] [PubMed]
- Pecoraro, L.; Girlanda, M.; Kull, T.; Perini, C.; Perotto, S. Analysis of fungal diversity in Orchis tridentata Scopoli. Open Life Sci. 2012, 7, 850–857. [Google Scholar] [CrossRef]
- Pereira, O.L.; Kasuya, M.C.M.; Borges, A.C.; De Araújo, E.F. Morphological and molecular characterization of mycorrhizal fungi isolated from neotropical orchids in Brazil. Can. J. Bot. 2005, 83, 54–65. [Google Scholar] [CrossRef]
- Otero, J.T.; Flanagan, N.S.; Herre, E.A.; Ackerman, J.D.; Bayman, P. Wide spread mycorrhizal specificity correlates to mycorrhizal function in the neotropical, epiphytic orchid Ionopsis utricularioides (Orchidaceae). Am. J. Bot. 2007, 94, 1944–1950. [Google Scholar] [CrossRef]
- Otero, J.T.; Bayman, P.; Ackerman, J.D. Variation in mycorrhizal performance in the epiphytic orchid Tolumnia variegata in vitro: The potential for natural selection. Evol. Ecol. 2005, 19, 29–43. [Google Scholar] [CrossRef]
- Carlsward, B.S.; Whitten, W.M.; Williams, N.H.; Bytebier, B. Molecular phylogenetics of Vandeae (Orchidaceae) and the evolution of leaflessness. Am. J. Bot. 2006, 93, 770–786. [Google Scholar] [CrossRef]
- Hoang, N.H.; Kane, M.E.; Radcliffe, E.N.; Zettler, L.W.; Richardson, L.W. Comparative seed germination and seedling development of the ghost orchid, Dendrophylax lindenii (Orchidaceae), and molecular identification of its mycorrhizal fungus from South Florida. Ann. Bot. 2016, 119, 379–393. [Google Scholar] [CrossRef]
- Richardson, K.; Currah, R.; Hambleton, S. Basidiomycetous endophytes from the roots of neotropical epiphytic Orchidaceae. Lindleyana 1993, 8, 127–137. [Google Scholar]
- Cameron, D.D.; Leake, J.R.; Read, D.J. Mutualistic mycorrhiza in orchids: Evidence from plant–fungus carbon and nitrogen transfers in the green-leaved terrestrial orchid Goodyera repens. New Phytol. 2006, 171, 405–416. [Google Scholar] [CrossRef]
- Shefferson, R.P.; Cowden, C.C.; McCormick, M.K.; Yukawa, T.; Ogura-Tsujita, Y.; Hashimoto, T. Evolution of host breadth in broad interactions: Mycorrhizal specificity in East Asian and North American rattlesnake plantains (Goodyera spp.) and their fungal hosts. Mol. Ecol. 2010, 19, 3008–3017. [Google Scholar] [CrossRef]
- Suetsugu, K.; Yamato, M.; Matsubayashi, J.; Tayasu, I. Comparative study of nutritional mode and mycorrhizal fungi in green and albino variants of Goodyera velutina, an orchid mainly utilizing saprotrophic rhizoctonia. Mol. Ecol. 2019, 28, 4290–4299. [Google Scholar] [CrossRef]
- Kristiansen, K.A.; Freudenstein, J.V.; Rasmussen, F.N.; Rasmussen, H.N. Molecular identification of mycorrhizal fungi in Neuwiedia veratrifolia (Orchidaceae). Mol. Phylogenetics Evol. 2004, 33, 251–258. [Google Scholar] [CrossRef]
- Pecoraro, L.; Huang, L.Q.; Caruso, T.; Perotto, S.; Girlanda, M.; Cai, L.; Liu, Z.J. Fungal diversity and specificity in Cephalanthera damasonium and C. longifolia (Orchidaceae) mycorrhizas. J. Syst. Evol. 2017, 55, 69–158. [Google Scholar] [CrossRef]
- Pecoraro, L.; Caruso, T.; Cai, L.; Gupta, V.K.; Liu, Z.-J. Fungal networks and orchid distribution: New insights from above- and below-ground analyses of fungal communities. IMA Fungus 2018, 9, 1–11. [Google Scholar] [CrossRef] [PubMed]
- Durán-López, M.; Caroca-Cáceres, R.; Jahreis, K.; Narváez-Vera, M.; Ansaloni, R.; Cazar, M. The micorryzal fungi Ceratobasidium sp. and Sebacina vermifera promote seed germination and seedling development of the terrestrial orchid Epidendrum secundum Jacq. S. Afr. J. Bot. 2019, 125, 54–61. [Google Scholar] [CrossRef]
- Yang, Q.Y.; He, C.F.; Liang, L.X.; Wang, T.; Liu, L. Effects of mycorrhizal fungi on the growth of three species of orchid seedlings. J. Nuclear Agric. Sci. 2019, 33, 0687–0695. [Google Scholar]
Publisher’s Note: MDPI stays neutral with regard to jurisdictional claims in published maps and institutional affiliations. |
© 2021 by the authors. Licensee MDPI, Basel, Switzerland. This article is an open access article distributed under the terms and conditions of the Creative Commons Attribution (CC BY) license (https://creativecommons.org/licenses/by/4.0/).